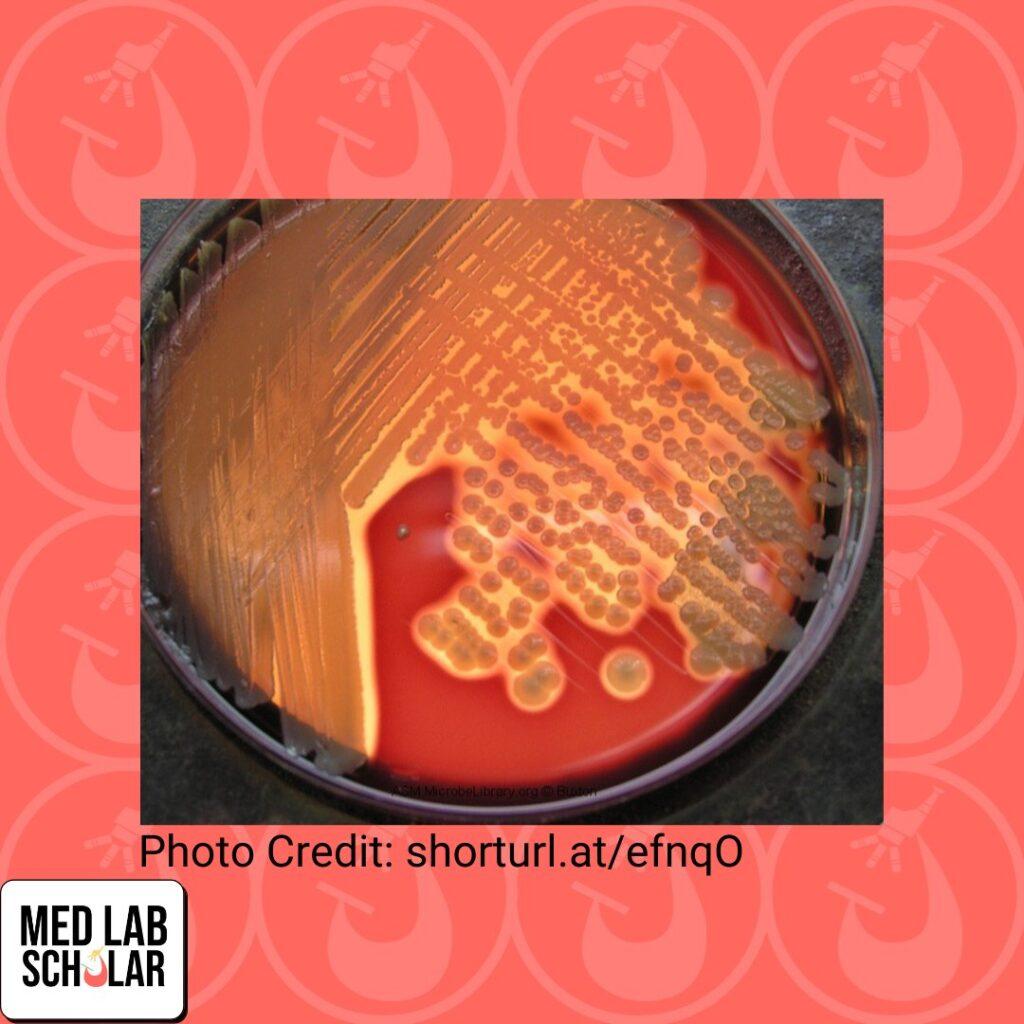
Swab sample of a wound had growth on a BA plate.

Swab sample of a wound had growth on a BA plate. Unfortunately, the MALDI-TOF mass spectrometry analyzer broke down. Based on the picture below what would be the first biochemical test you would perform and its expected result? What organism do you suspect?
Day 21: March 8th, 2022
Answer
Perform a catalase test (expected to be positive). Most likely Staphylococcus aureus.